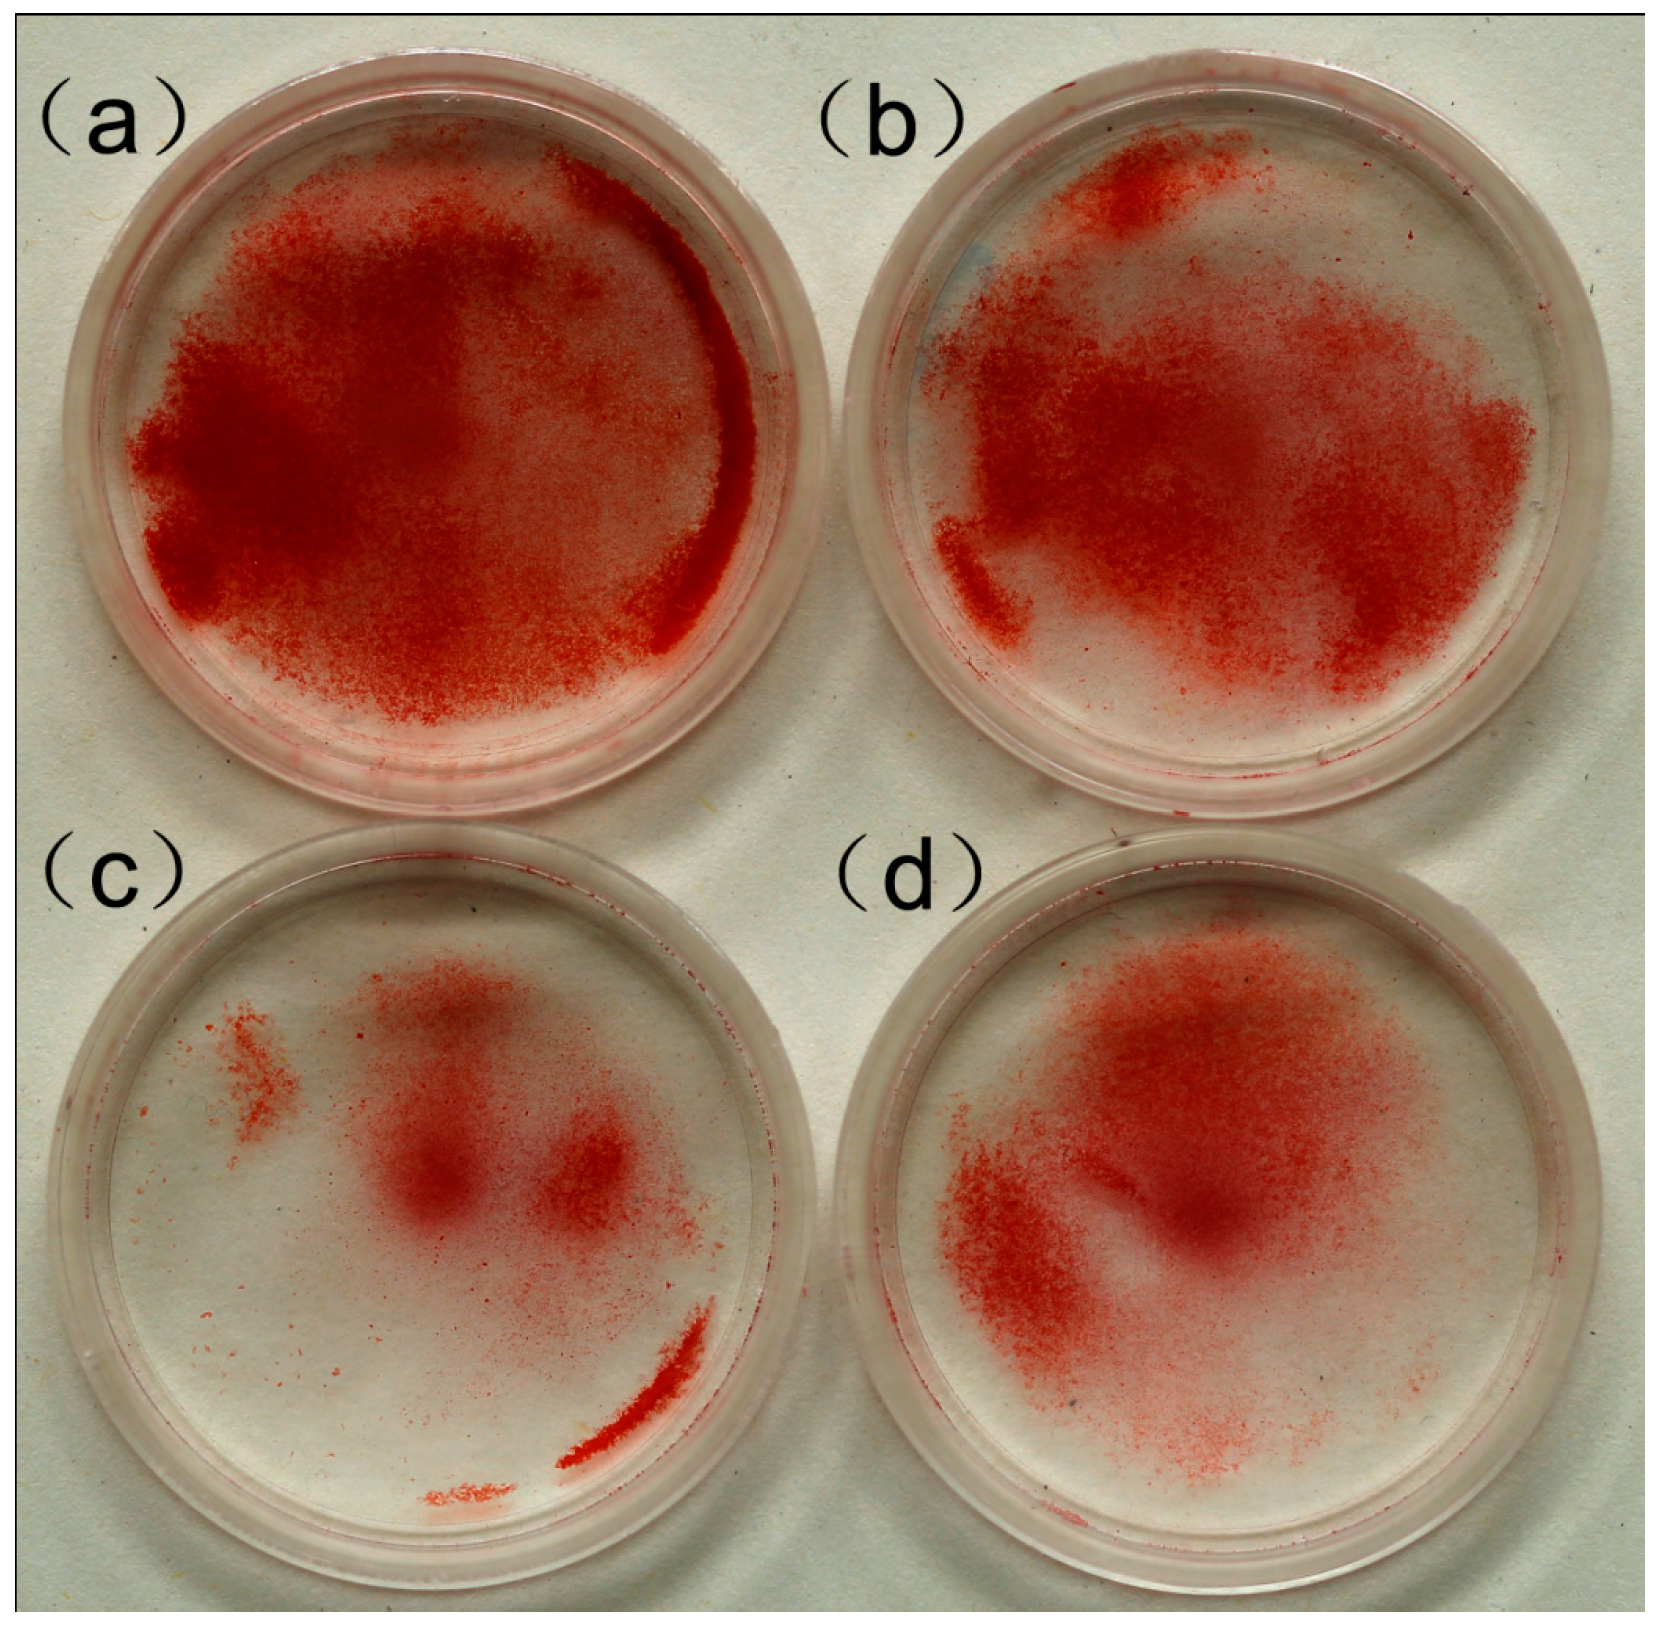

Multi-Walled Carbon Nanotubes Promote Cementoblast Differentiation and Mineralization through the TGF-β/Smad Signaling Pathway
Abstract
:1. Introduction
2. Results
2.1. Cytotoxicity of Carboxyl Group-Functionalized Multi-Walled Carbon Nanotubes (MWCNT-COOH)

2.2. Assessments of the Material Structure and Cell Growth

2.3. Effect of MWCNT-COOH on the Mineralization of Cementoblasts
2.3.1. Effects of MWCNT-COOH on OCCM-30 Cementoblast Gene Expression: Dose Response
2.3.2. Effects of MWCNT-COOH on OCCM-30 Cementoblast Gene Expression: Time Course


2.4. Effects of MWCNT-COOH on OCCM-30 Cementoblast Smad Proteins

3. Discussion
4. Experimental Section
4.1. Preparation of MWCNT-COOH Solution
4.2. Cell Culture
4.3. Cell Viability Assay
4.4. Assessments of the Material Structure and Cell Growth
4.5. Alizarin Red Staining
4.6. RNA Isolation and Quantitative Real-Time PCR (qRT-PCR)
| Genes | Primer Sequence | GenBank Number |
|---|---|---|
| Smad1 | F: 5'-ACCTGCTTACCTGCCTCCTGA-3' | NM_008539.3 |
| R: 5'-GCAACTGCCTGAACATCTCCTCT-3' | ||
| Smad2 | F: 5'-TTCACAGACCCATCAAACTCGG-3' | NM_001252481.1 |
| R: 5'-CTATCACTTAGGCACTCAGCAAACA-3' | ||
| Smad3 | F: 5'-GACCACCAGATGAACCACAGCA-3' | NM_016769.4 |
| R: 5'-TAGGAGATGGAGCACCAGAAGG-3' | ||
| Smad6 | F: 5'-AGGTGTTCGACTTTGAGCGC-3' | NM_008542.3 |
| R: 5'-CAGGAGGTGATGAACTGTCGC-3' | ||
| Smad7 | F: 5'-GCTGTCCAGATGCTGTACCTTCC-3' | NM_001042660.1 |
| R: 5'-GAGTCTTCTCCTCCCAGTATGCC-3' | ||
| Col1 | F: 5'-GCATAAAGGGTCATCGTGGCT-3' | NM_007742.3 |
| R: 5'-CCGTTGAGTCCGTCTTTGCC-3' | ||
| Ocn | F: 5'-GGACCATCTTTCTGCTCACTCTG-3' | NM_001037939.2 |
| R: 5'-ACCTTATTGCCCTCCTGCTTG-3' | ||
| Opn | F: 5'-TGATGAACAGTATCCTGATGCCA-3' | NM_001204201.1 |
| R: 5'-CTGCCCTTTCCGTTGTTGTC-3' | ||
| Bsp | F: 5'-GAATACGAACAAACAGGCAACG-3' | NM_008318.3 |
| R: 5'-CATCCTCATAAGCTCGGTAAGTGTC-3' | ||
| Alp | F: 5'-ACAACCTGACTGACCCTTCGC-3' | NM_001287172.1 |
| R: 5'-CAATCCTGCCTCCTTCCACC-3' | ||
| Gapdh | F: 5'-ACCACAGTCCATGCCATCAC-3' | NM_008084.2 |
| R: 5'-TCCACCACCCTGTTGCTGTA-3' | ||
| Runx2 | F: 5'-GCCACCTCTGACTTCTGCCTCT-3' | NM_001145920.2 |
| R: 5'-CAGTGAGGGATGAAATGCTTGG-3' |
4.7. Western Blot
4.8. Statistical Analysis
5. Conclusions
Acknowledgments
Author Contributions
Conflicts of Interest
References
- Saygin, N.E.; Giannobile, W.V.; Somerman, M.J. Molecular and cell biology of cementum. Periodontology 2000 2000, 24, 73–98. [Google Scholar] [CrossRef] [PubMed]
- Harrison, J.W.; Roda, R.S. Intermediate cementum: Development, structure, composition, and potential functions. Oral Surg. Oral Med. Oral Pathol. Oral Radiol. Endod. 1995, 79, 624–633. [Google Scholar] [CrossRef] [PubMed]
- Grzesik, W.J.; Narayanan, A.S. Cementum and periodontal wound healing and regeneration. Crit. Rev. Oral Biol. Med. 2002, 13, 474–484. [Google Scholar] [CrossRef] [PubMed]
- Bosshardt, D.D. Are cementoblasts a subpopulation of osteoblasts or a unique phenotype. J. Dent. Res. 2005, 84, 390–406. [Google Scholar] [CrossRef] [PubMed]
- Oringer, R.J. Biological mediators for periodontal and bone regeneration. Compend. Contin. Educ. Dent. 2002, 23, 501–504, 506–510, 512–518. [Google Scholar] [PubMed]
- Bosshardt, D.D. Biological mediators and periodontal regeneration: A review of enamel matrix proteins at the cellular and molecular levels. J. Clin. Periodontol. 2008, 35, 87–105. [Google Scholar] [CrossRef] [PubMed]
- Kumazawa, R.; Watari, F.; Takashi, N.; Tanimura, Y.; Uo, M.; Totsuka, Y. Effects of Ti ions and particles on neutrophil function and morphology. Biomaterials 2002, 23, 3757–3764. [Google Scholar] [CrossRef] [PubMed]
- Yim, E.K.; Leong, K.W. Significance of synthetic nanostructures in dictating cellular response. Nanomedicine 2005, 1, 10–21. [Google Scholar] [CrossRef] [PubMed]
- Li, X.; van Blitterswijk, C.A.; Feng, Q.; Cui, F.; Watari, F. The effect of calcium phosphate microstructure on bone-related cells in vitro. Biomaterials 2008, 29, 3306–3316. [Google Scholar] [CrossRef] [PubMed]
- Li, X.; Liu, H.; Niu, X.; Yu, B.; Fan, Y.; Feng, Q.; Cui, F.Z.; Watari, F. The use of carbon nanotubes to induce osteogenic differentiation of human adipose-derived MSCs in vitro and ectopic bone formation in vivo. Biomaterials 2012, 33, 4818–4827. [Google Scholar] [CrossRef] [PubMed]
- Iijima, S. Helical microtubules of graphitic carbon. Nature 1991, 354, 56–58. [Google Scholar] [CrossRef]
- Ajayan, P.M. Nanotubes from Carbon. Chem. Rev. 1999, 99, 1787–1800. [Google Scholar] [CrossRef] [PubMed]
- Tutak, W.; Park, K.H.; Vasilov, A.; Starovoytov, V.; Fanchini, G.; Cai, S.Q.; Partridge, N.C.; Sesti, F.; Chhowalla, M. Toxicity induced enhanced extracellular matrix production in osteoblastic cells cultured on single-walled carbon nanotube networks. Nanotechnology 2009, 20, 255101–255108. [Google Scholar] [CrossRef] [PubMed]
- Vardharajula, S.; Ali, S.Z.; Tiwari, P.M.; Eroglu, E.; Vig, K.; Dennis, V.A.; Singh, S.R. Functionalized carbon nanotubes: Biomedical applications. Int. J. Nanomed. 2012, 7, 5361–5374. [Google Scholar]
- Zhang, Y.; Bai, Y.; Yan, B. Functionalized carbon nanotubes for potential medicinal applications. Drug Discov. Today 2010, 15, 428–435. [Google Scholar] [CrossRef] [PubMed]
- Massague, J. TGF-β signal transduction. Annu. Rev. Biochem 1998, 67, 753–791. [Google Scholar] [CrossRef]
- Whitman, M. Smads and early developmental signaling by the TGFβ superfamily. Genes. Dev. 1998, 12, 2445–2462. [Google Scholar] [CrossRef] [PubMed]
- Warheit, D.B.; Laurence, B.R.; Reed, K.L.; Roach, D.H.; Reynolds, G.A.; Webb, T.R. Comparative pulmonary toxicity assessment of single-wall carbon nanotubes in rats. Toxicol. Sci. 2004, 77, 117–125. [Google Scholar] [CrossRef] [PubMed]
- Yang, H.; Liu, C.; Yang, D.; Zhang, H.; Xi, Z. Comparative study of cytotoxicity, oxidative stress and genotoxicity induced by four typical nanomaterials: the role of particle size, shape and composition. J. Appl. Toxicol. 2009, 29, 69–78. [Google Scholar] [CrossRef] [PubMed]
- Zhang, Y.; Ali, S.F.; Dervishi, E.; Xu, Y.; Li, Z.; Casciano, D.; Biris, A.S. Cytotoxicity effects of graphene and single-wall carbon nanotubes in neural phaeochromocytoma-derived PC12 cells. ACS Nano 2010, 4, 3181–3186. [Google Scholar] [CrossRef] [PubMed]
- Sasidharan, A.; Panchakarla, L.S.; Chandran, P.; Menon, D.; Nair, S.; Rao, C.N.; Koyakutty, M. Differential nano-bio interactions and toxicity effects of pristine versus functionalized graphene. Nanoscale 2011, 3, 2461–2464. [Google Scholar] [CrossRef] [PubMed]
- Liu, D.; Yi, C.; Zhang, D.; Zhang, J.; Yang, M. Inhibition of proliferation and differentiation of mesenchymal stem cells by carboxylated carbon nanotubes. ACS Nano 2010, 4, 2185–2195. [Google Scholar] [CrossRef] [PubMed]
- Mahmood, M.; Villagarcia, H.; Dervishi, E.; Mustafa, T.; Alimohammadi, M.; Casciano, D.; Khodakovskaya, M.; Biris, A.S. Role of carbonaceous nanomaterials in stimulating osteogenesis in mammalian bone cells. J. Mater. Chem. 2013, 1, 3220–3230. [Google Scholar] [CrossRef]
- Saffar, K.P.; Arshi, A.R.; JamilPour, N.; Najafi, A.R.; Rouhi, G.; Sudak, L. A cross-linking model for estimating Young’s modulus of artificial bone tissue grown on carbon nanotube scaffold. J. Biomed. Mater. Res. 2010, 94, 594–602. [Google Scholar]
- Usui, Y.; Aoki, K.; Narita, N.; Murakami, N.; Nakamura, I.; Nakamura, K.; Ishigaki, N.; Yamazaki, H.; Horiuchi, H.; Kato, H.; et al. Carbon nanotubes with high bone-tissue compatibility and bone-formation acceleration effects. Small 2008, 4, 240–246. [Google Scholar]
- Boskey, A.L.; Maresca, M.; Ullrich, W.; Doty, S.B.; Butler, W.T.; Prince, C.W. Osteopontin-hydroxyapatite interactions in vitro: Inhibition of hydroxyapatite formation and growth in a gelatin-gel. Bone Miner. 1993, 22, 147–159. [Google Scholar] [CrossRef] [PubMed]
- Yang, S.; Wei, D.; Wang, D.; Phimphilai, M.; Krebsbach, P.H.; Franceschi, R.T. In vitro and in vivo synergistic interactions between the Runx2/Cbfa1 transcription factor and bone morphogenetic protein-2 in stimulating osteoblast differentiation. J. Bone Miner. Res. 2003, 18, 705–715. [Google Scholar] [CrossRef] [PubMed]
- Ripamonti, U.; Ferretti, C.; Teare, J.; Blann, L. Transforming growth factor-beta isoforms and the induction of bone formation: implications for reconstructive craniofacial surgery. J. Craniofac. Surg. 2009, 20, 1544–1555. [Google Scholar] [CrossRef] [PubMed]
- Ripamonti, U.; Parak, R.; Petit, J.C. Induction of cementogenesis and periodontal ligament regeneration by recombinant human transforming growth factor-β3 in Matrigel with rectus abdominis responding cells. J. Periodontal Res. 2009, 44, 81–87. [Google Scholar] [CrossRef] [PubMed]
- Houshmand, B.; Behnia, H.; Khoshzaban, A.; Morad, G.; Behrouzi, G.; Dashti, S.G.; Khojasteh, A. Osteoblastic differentiation of human stem cells derived from bone marrow and periodontal ligament under the effect of enamel matrix derivative and transforming growth factor-β. Int. J. Oral Maxillofac. Implant. 2013, 28, e440–e450. [Google Scholar] [CrossRef]
- Klar, R.M.; Duarte, R.; Dix-Peek, T.; Ripamonti, U. The induction of bone formation by the recombinant human transforming growth factor-β3. Biomaterials 2014, 35, 2773–2788. [Google Scholar] [CrossRef] [PubMed]
- Heldin, C.H.; Miyazono, K.; Ten, D.P. TGF-β signalling from cell membrane to nucleus through SMAD proteins. Nature 1997, 390, 465–471. [Google Scholar] [CrossRef] [PubMed]
- Zhang, Y.; Mu, Q.; Zhou, H.; Vrijens, K.; Roussel, M.F.; Jiang, G.; Yan, B. Binding of carbon nanotube to BMP receptor 2 enhances cell differentiation and inhibits apoptosis via regulating bHLH transcription factors. Cell Death Dis. 2012, 3, e308. [Google Scholar] [CrossRef] [PubMed]
- Ducy, P.; Zhang, R.; Geoffroy, V.; Ridall, A.L.; Karsenty, G. Osf2/Cbfa1: A transcriptional activator of osteoblast differentiation. Cell 1997, 89, 747–754. [Google Scholar] [CrossRef] [PubMed]
- Otto, F.; Thornell, A.P.; Crompton, T.; Denzel, A.; Gilmour, K.C.; Rosewell, I.R.; Stamp, G.W.; Beddington, R.S.; Mundlos, S.; Olsen, B.R.; et al. Cbfa1, a candidate gene for cleidocranial dysplasia syndrome, is essential for osteoblast differentiation and bone development. Cell 1997, 89, 765–771. [Google Scholar]
- Sevetson, B.; Taylor, S.; Pan, Y. Cbfa1/RUNX2 directs specific expression of the sclerosteosis gene (SOST). J. Biol. Chem. 2004, 279, 13849–13858. [Google Scholar] [CrossRef] [PubMed]
- Miyazono, K.; Kamiya, Y.; Morikawa, M. Bone morphogenetic protein receptors and signal transduction. J. Biochem. 2010, 147, 35–51. [Google Scholar] [CrossRef] [PubMed]
- Leboy, P.; Grasso-Knight, G.; D'Angelo, M.; Volk, S.W.; Lian, J.V.; Drissi, H.; Stein, G.S.; Adams, S.L. Smad–Runx interactions during chondrocyte maturation. J. Bone Jt. Surg. Am. 2001, 83, 15–22. [Google Scholar]
- Hu, W.; Yuan, L.; Chen, Z.; Gong, D.; Saito, K. Fabrication and characterization of vertically aligned carbon nanotubes on silicon substrates using porous alumina nanotemplates. J. Nanosci. Nanotechnol. 2002, 2, 203–207. [Google Scholar] [CrossRef] [PubMed]
- Wei, X.; Juan, Z.X.; Min, F.X.; Nan, C.; Hua, Z.X.; Qing, F.Z.; Zheng, L. Recombinant immunotoxin anti-c-Met/PE38KDEL inhibits proliferation and promotes apoptosis of gastric cancer cells. J. Exp. Clin. Cancer Res. 2011, 30, 67–73. [Google Scholar] [CrossRef] [PubMed]
© 2015 by the authors; licensee MDPI, Basel, Switzerland. This article is an open access article distributed under the terms and conditions of the Creative Commons Attribution license (http://creativecommons.org/licenses/by/4.0/).
Share and Cite
Li, L.; Zhu, Z.; Xiao, W.; Li, L. Multi-Walled Carbon Nanotubes Promote Cementoblast Differentiation and Mineralization through the TGF-β/Smad Signaling Pathway. Int. J. Mol. Sci. 2015, 16, 3188-3201. https://doi.org/10.3390/ijms16023188
Li L, Zhu Z, Xiao W, Li L. Multi-Walled Carbon Nanotubes Promote Cementoblast Differentiation and Mineralization through the TGF-β/Smad Signaling Pathway. International Journal of Molecular Sciences. 2015; 16(2):3188-3201. https://doi.org/10.3390/ijms16023188
Chicago/Turabian StyleLi, Lu, Zhimin Zhu, Weixiong Xiao, and Lei Li. 2015. "Multi-Walled Carbon Nanotubes Promote Cementoblast Differentiation and Mineralization through the TGF-β/Smad Signaling Pathway" International Journal of Molecular Sciences 16, no. 2: 3188-3201. https://doi.org/10.3390/ijms16023188
APA StyleLi, L., Zhu, Z., Xiao, W., & Li, L. (2015). Multi-Walled Carbon Nanotubes Promote Cementoblast Differentiation and Mineralization through the TGF-β/Smad Signaling Pathway. International Journal of Molecular Sciences, 16(2), 3188-3201. https://doi.org/10.3390/ijms16023188
